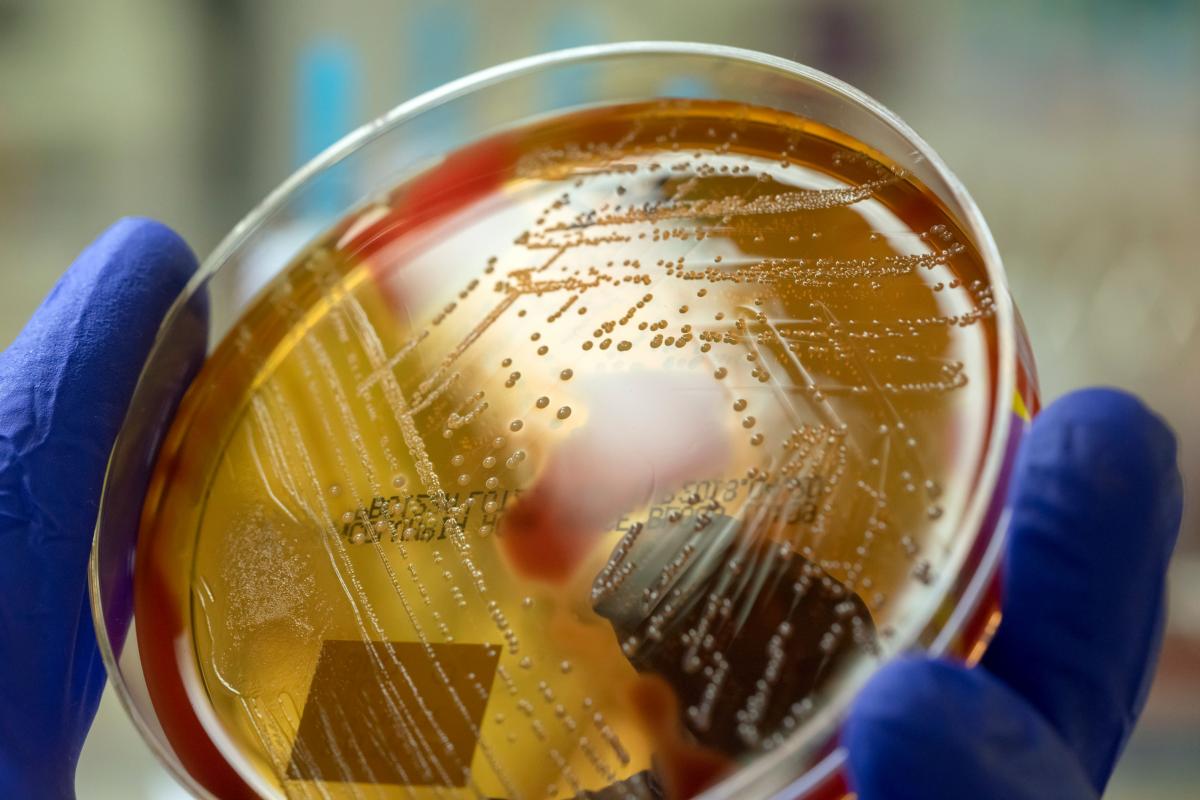

Estreptococo A: síntomas, vacunas, tratamiento y cómo se contagia
Todo lo que tienes que saber tras los casos de niños fallecidos y hospitalizados en España, Reino Unido o Francia por la enfermedad invasiva de este tipo de bacteria.
Lo que comenzó como un goteo de casos de niños muertos en Reino Unido y Francia tras contraer la enfermedad invasiva del estreptococo A ha llegado a España. Dos menores han muerto y otros 14 han precisado ingreso hospitalario en la Comunidad de Madrid en las últimas semanas tras llegar a los servicios de urgencias hospitalarios con un cuadro clínico de evolución muy severa.
El Ministerio de Sanidad ya había anunciado que estaba investigando, mano a mano con las comunidades autónomas, los casos tras conocerse el fallecimiento de nueve niños en territorio británico. Ante esta situación, han comenzado a aflorar las dudas sobre las denominadas bacterias del Streptococcus del grupo A.
¿Hay una vacuna efectiva? ¿Cuáles son sus síntomas y en qué se diferencia de otras bacterias? Y, sobre todo, ¿cómo puede evitarse el contagio? Estas son las respuestas a las principales incógnitas sobre esta dolencia.
¿Qué son los estreptococos?
Lo primero que hay que saber es que la bacteria del Streptococcus cuenta con distintas tipologías que determinan cómo afecta al organismo y en qué grado. En este sentido, el género se divide en varios grupos que pueden causar enfermedades en los seres humanos.
El grupo A está producido por la Streptococcus pyogenes y pueden derivarse en amigdalitis e impétigo. Si hablamos del grupo B, el más común, se corresponde con la Streptococcus agalactiae, que puede desembocar en meningitis en neonatos, causando trastornos del embarazo en la mujer. A ellos se suman la Streptococcus pneumoniae (o neumococo) que está detrás de buena parte de las neumonías y otras formas como la Streptococcus viridans (que puede traducirse en endocarditis o abscesos dentales) y dentro de esta la Streptococcus mutans (motivo de muchas caries dentales.
¿En qué se diferencia el grupo A?
Según el Centro de Disuasión y Control de Enfermedades (CDC) de Estados Unidos -país en el que se han desarrollado buena parte de las investigaciones sobre esta dolencia-, las infecciones de garganta por estreptococos son infecciones tanto de la garganta como de las amígdalas, causadas por unas bacterias llamadas Streptococcus del grupo A (estreptococos del grupo A). Estamos hablando de infecciones de garganta leves, pero que pueden llegar a ser muy dolorosas.
Con todo, son una de las 10 causas principales de muerte por enfermedades infecciosas en todo el mundo y se estima que causa más de medio millón de muertes por año, principalmente en regiones subdesarrolladas o con menor nivel de riqueza.
¿Cómo se contagia este estreptococo y cómo puedo evitarlo?
Los estreptococos del grupo A habitan en la nariz y la garganta, por lo que pueden transmitirse con cierta facilidad. Los infectados transmiten las bacterias al hablar, toser o estornudar, de una forma similar a la que lo hace, por ejemplo, el coronavirus. Se crean gotitas respiratorias que contienen bacterias y circulan por vía aérea, pero estas también pueden propagar las bacterias a través de las llagas infectadas en la piel. En muy extrañas ocasiones, esta bacteria también puede ser transmitida a través de alimentos no manipulados de forma correcta.
En lo relativo a la forma de evitar contagios, muchos de los pasos a seguir son de sobra conocidos para la población, tras la crisis sanitaria del coronavirus:
- Cubrirse la nariz y la boca con un pañuelo desechable cuando tosa o estornude.
- Botar el pañuelo desechable usado a la basura.
- Si no tiene un pañuelo desechable cuando tosa o estornude, debe cubrirse la nariz y la boca con la parte superior del brazo o el codo, no las manos.
- Lavarse frecuentemente las manos con agua y jabón por al menos 20 segundos.
- Usar un desinfectante de manos a base de alcohol si no tiene agua y jabón disponibles.
¿Cuáles son los síntomas?
Habitualmente, el período de incubación es de entre dos y cinco días para que una persona expuesta a estreptococos del grupo A enferme debido a una infección de garganta por estreptococos. Lo cierto es que los síntomas más leves están bien definidos y son los siguientes:
- Dolor de garganta que puede comenzar muy rápidamente.
- Dolor al tragar.
- Fiebre.
- Enrojecimiento e inflamación de las amígdalas, a veces, con manchas blancas o placas de pus.
- Pequeños puntitos rojos (petequias) en el paladar (duro o blando).
- Inflamación de los ganglios linfáticos del cuello.
¿Cómo se agrava esta infección y qué supone?
En el caso de que las bacterias se propaguen a otras partes del cuerpo, pueden aparecer complicaciones importantes. Estas son las principales:
- Abscesos (sacos de pus) alrededor de las amígdalas.
- Inflamación de los ganglios linfáticos del cuello.
- Sinusitis (infección de los senos paranasales).
- Infecciones de oído.
- Fiebre reumática (enfermedad cardiaca).
- Glomerulonefritis posestreptocócica (enfermedad renal).
¿Qué conlleva la enfermedad invasiva y sus dos formas más graves?
No obstante, hay dos formas especialmente graves, pero menos comunes. Precisamente, las que han acabado con la vida de las dos pequeñas en España. Se trata de cuando adopta la enfermedad invasiva y se deriva en “fascitis necrotizante” (infección del tejido graso y muscular) o en el “síndrome de shock tóxico estreptocócico” (infección de evolución rápida que produce hipotensión/shock y lesiones de órganos como los riñones, el hígado y los pulmones).
En cifras recogidas en Estados Unidos, aproximadamente el 20% de los pacientes que sufren fascitis necrotizante y 60% de las que padecen el síndrome acaban muriendo. Sólo entre un 10% y un 15% de los pacientes que sufren otras formas de enfermedad estreptocócica invasiva del grupo A muere.
¿Cómo puedo saber si estoy infectado?
Lo primero es acudir a un centro sanitario y ser examinado por un médico. Si el profesional sanitario sospecha que se trata de una infección por estreptococos recogerá una muestra para someterla a análisis. De esta forma, hay dos tipos de prueba: la prueba rápida y el cultivo de garganta.
La prueba rápida consiste en tomar una muestra de la garganta con un bastoncito de algodón (hisopo) y analizarla. Esta prueba muestra rápidamente si la causa de la enfermedad son estreptococos del grupo A. Si la prueba da positivo, el médico puede recetar antibióticos. Si da negativo, pero el médico aún sospecha que se trate de una infección por estreptococos, puede tomar otra muestra de garganta para cultivo.
En el caso del cultivo, tarda en mostrar si crecen bacterias estreptocócicas del grupo A a partir de la muestra. No obstante, aunque tomen más tiempo, se pueden identificar infecciones que las pruebas rápidas no detectan. Es importante hacer cultivos en los niños y adolescentes porque las infecciones de garganta por estreptococos no tratadas pueden causarles fiebre reumática. Los adultos generalmente no necesitan cultivos de garganta después de una prueba rápida negativa. Esto se debe a que generalmente no están en riesgo de presentar fiebre reumática tras una infección de garganta por estreptococos.
¿Cuál es el tratamiento?
Los médicos tratan las infecciones de garganta por estreptococos con antibióticos. La penicilina o la amoxicilina son los antibióticos de primera elección recomendados para las personas no alérgicas a la penicilina. Sin embargo, se pueden emplear otros tipos de antibióticos en su reemplazo. A los dos días debería notarse la mejoría.
Los antibióticos afectan de la siguiente forma a los infectados:
- Reducen el tiempo de enfermedad.
- Alivian los síntomas (el paciente siente mejoría, en líneas generales).
- Previenen la transmisión de las bacterias a otras personas.
- Previenen las complicaciones graves, como la fiebre reumática.
Cabe destacar que en el caso de los asintomáticos no suele ser necesario aplicar un tratamiento con antibióticos. El motivo es que estas personas tienen menos probabilidades de transmitir la bacteria y muchas menos probabilidades de presentar complicaciones.
¿Hay vacuna?
Desafortunadamente, a día de hoy no existe una vacuna efectiva contra este grupo. La búsqueda se ve obstaculizada por la variedad de cepas de estreptococo A. Hasta ahora, la mayor parte de la información proviene de áreas de altos ingresos como el Reino Unido y Estados Unidos, si bien se sabe muy poco acerca de la estreptococo A en las áreas de bajos ingresos del mundo donde causa más problemas. Esto significa que las vacunas candidatas actuales pueden no ser efectivas en todas las áreas.
Sin embargo, en 2019, investigadores del Instituto Wellcome Sanger, la Universidad de Cambridge, el Instituto Peter Doherty para la Infección e Inmunidad (Instituto Doherty) en Australia y la Universidad de Queensland, Australia identificaron una posible vacuna contra la mayoría de cepas del estreptococo.
Publicado en Nature Genetics, el proyecto, que ha abarcado una década, ha identificado que había algunas dianas moleculares presentes en cepas bacterianas de los 20 países, incluidos el Reino Unido, Australia y la India, que apuntan a la posibilidad de desarrollar una vacuna global eficaz contra el estreptococo A.
